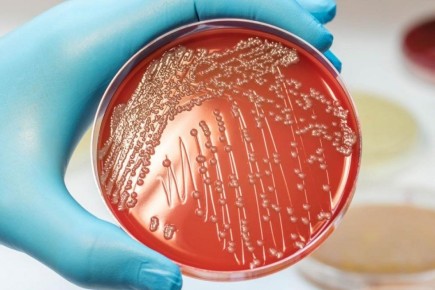
��� ����, ��� �������� ����� ���� ��� ������?

Топ
Совсем скоро подойдет время очередного теста на экономию. Ах, как прекрасно, когда можно накормить семью из четырех человек и при этом не разориться! В этой статье подготовлено меню за два дня для семейного ужина с учетом разумных затрат...
Кулинарный мир предлагает множество вариантов супов, способных удивить и порадовать ваших близких. Ниже представляем несколько интересных рецептов, которые легко приготовить и приятно подать.
Разнообразие супов на любой вкус
Суп-пюре из кабачков и...
Кабачковая лепешка — это универсальное блюдо, которое легко готовить и наслаждаться в любое время суток. Будь то завтрак или ужин, этот рецепт всегда станет удачным выбором для любителей простых и полезных блюд, сообщает Рецепты ПП -...
Салаты — это не только полезно, но и вкусно! Особенно когда речь идет о простых рецептах, которые не требуют много времени на подготовку. В условиях быстрого темпа жизни многие ищут варианты легких и полезных блюд, и салат-венок станет...
Не нужно варить, закатывать или стерилизовать — достаточно залить огурцы рассолом и дать им настояться. Результат? Настоящие огурцы из детства: хрустящие, с ярким ароматом укропа и чеснока, будто вы только что вынули их из дубовой бочки!
И это не...
Пирог «Вулкан» — это настоящее кулинарное открытие для любителей простых и вкусных десертов. Он удивляет своей нежностью и насыщенным вкусом, а также минимальными усилиями на подготовку. Всего лишь соберите необходимые ингредиенты, объедините их в...
Кексы из сгущенки – это просто находка для любителей домашней выпечки. Готовятся они за считанные минуты, а для их приготовления нужен минимальный набор ингредиентов, пишет ЧТО ГОТОВИТЬ.
Что понадобится для кексов? 190 граммов сгущенного молока; 1...
Представляем вашему вниманию рецепт идеальной начинки для блинчиков, которая покорит сердца и желудки ваших близких. Эта нежная и вкусная начинка, без сомнений, станет настоящим хитом на вашем столе!
Секреты идеальной начинки
Для тех, кто не любит...
Согласно недавнему исследованию Роскачества, 20 популярных марок вареников с картошкой неожиданно оказались под горячим микроскопом. В числе «экспертов» значатся известных бренды, такие как «ВкусВилла», «Сытый папа» и Ozon fresh. Однако, ни один...
Сушка хурмы в электросушилке — это великолепный способ сохранить сладкий вкус и питательные свойства этого полезного фрукта. Процесс сушки достаточно прост, если следовать нескольким важным шагам.
Выбор и подготовка...
Индейка становится все более популярным выбором для новогоднего стола, вытесняя традиционные тяжелые блюда. Это мясо привлекает своей легкостью, питательностью и нежным вкусом. Запеченные голени индейки с овощами представляют собой...
Столовые тефтели иногда напоминают плотные облатки, а домашние порой расползаются в кашу. Для многих решение этой проблемы заключается в обжаривании в большом количестве масла и муки, что приводит к тяжёлому и жирному блюду.
Однако существует способ...
Свинина с луком и морковью на сковороде – это простое, но невероятно вкусное блюдо, которое станет отличным выбором для обеда или ужина. Оно прекрасно сочетается с гарниром из риса, картофельного пюре или разных круп. Сочное мясо и сладкие овощи...
Тарталетки с красной рыбой и авокадо — это не просто закуска, а настоящая кулинарная находка для праздничного застолья. Нежный крем из авокадо идеально гармонирует со слабосоленой рыбой, а свежий огурец привносит в блюдо ноту свежести. И все это...
Картофель фри - это не просто закуска, а настоящая кулинарная сенсация, ставшая символом уличной еды по всему миру. За его популярностью стоит интересная история, в которой переплетаются ошибки и недопонимания на географической карте.
От Бельгии к...
Эти шоколадные рулетики просто созданы для уютного чаепития. Их приготовление не займет много времени, а основные шаги могут выполнить даже дети. Пока рулетики подрумяниваются в духовке, есть возможность подготовить кочан свежего...
С наступлением весны пришло время побаловать себя и близких фаршированными овощами. Перцы, кабачки, баклажаны и помидоры — разнообразие овощей просто великолепно, и каждый из них может стать отличной основой для вкусной начинки. Особенно популярны...
Свекла — это не просто ингредиент для борща или винегрета. Эта универсальная корнеплодная звезда становится все более популярной в современных рецептах. Например, австралийский шеф-повар Глен Баллис, работающий в петербургском ресторане «Кузня»...
В век стремительного образа жизни и постоянного потока информации наряду с осознанным потреблением пищи особенно важно понимать, почему уровень сахара в крови может подниматься даже при соблюдении правильного рациона. Недавно в...
Представляем вашему вниманию невероятный рецептик: сочные утиные ножки, сочетающиеся с яркими цитрусовыми нотками мандаринов. На приготовление этой изысканной блюда потребуется совсем немного времени и всего лишь четыре ингредиента. Убедитесь, что...
Лента новостей
Лента
Топ